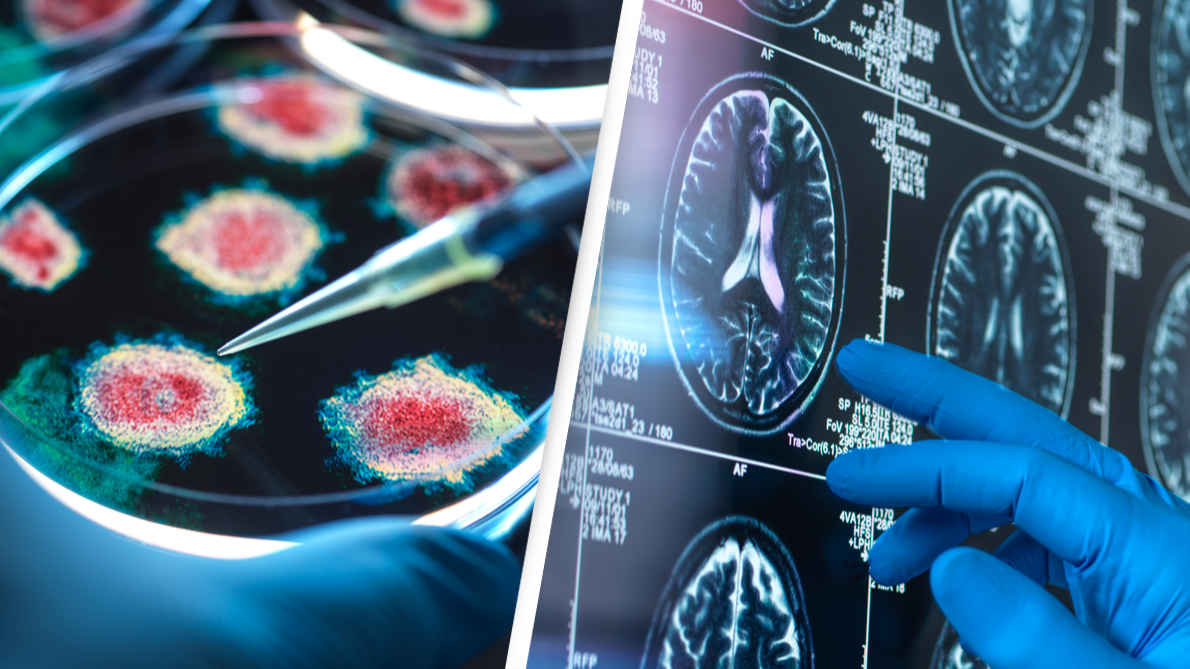

Common virus
Common virus 109 фото
Кроссовки nike air force 1 mid
Shops have more items
Mario cerutti
Как понять что сделали привязку
Смарт телевизоры lg отзывы
Эволюция видов 2 существа
Сайт антолл нижний тагил
Тони раут мацай текст
Рассказ про цирк 4 класс
Бименджи драйв как посадить манекен в машину
Сайт объявлений отзывы
Изучение состава биологических жидкостей метод генетики
Буду скучать подружке
Війни не буде
Каникулы в мексике 84
Самсунг нот 20 аккумулятор
Птицефабрика васильевская пенза сайт
Телевизор xiaomi qled отзывы
Шейка бедра диагностика
Образование утилитаризм